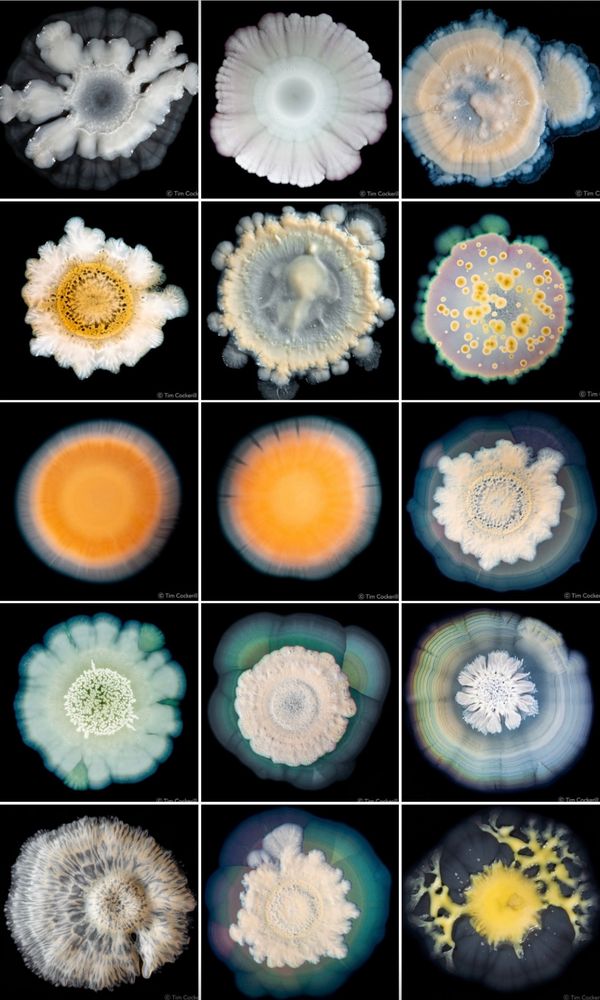
Several images of artistic-looking bacteria photographed by Dr. Tim Cockerill.

(Banner: Alan Reynolds. 'Spring's Riverbed', 1953. Ink, watercolour, and gouache).
She / Her

University 🧪🦠




- Candyman (1992)
- The Texas Chainsaw Massacre (1974)
- Suspiria (1977)
- The Lost Boys
- Texas Chainsaw Massacre
- The Wicker Man
- Halloween
- Suspiria
I'll go first:
-Silence of the Lambs
-I Saw the Devil
-Coherence
-Jaws
- Candyman (1992)
- The Texas Chainsaw Massacre (1974)
- Suspiria (1977)
- The Lost Boys










Here it is:
youtu.be/SfyO2T5kfxk?...

Here it is:
youtu.be/SfyO2T5kfxk?...

The studio will now be restored and brought back into public use, creating a new venue for creative arts in the Scottish Borders.

Image: RA.

Image: RA.
University 🧪🦠
University 🧪🦠





